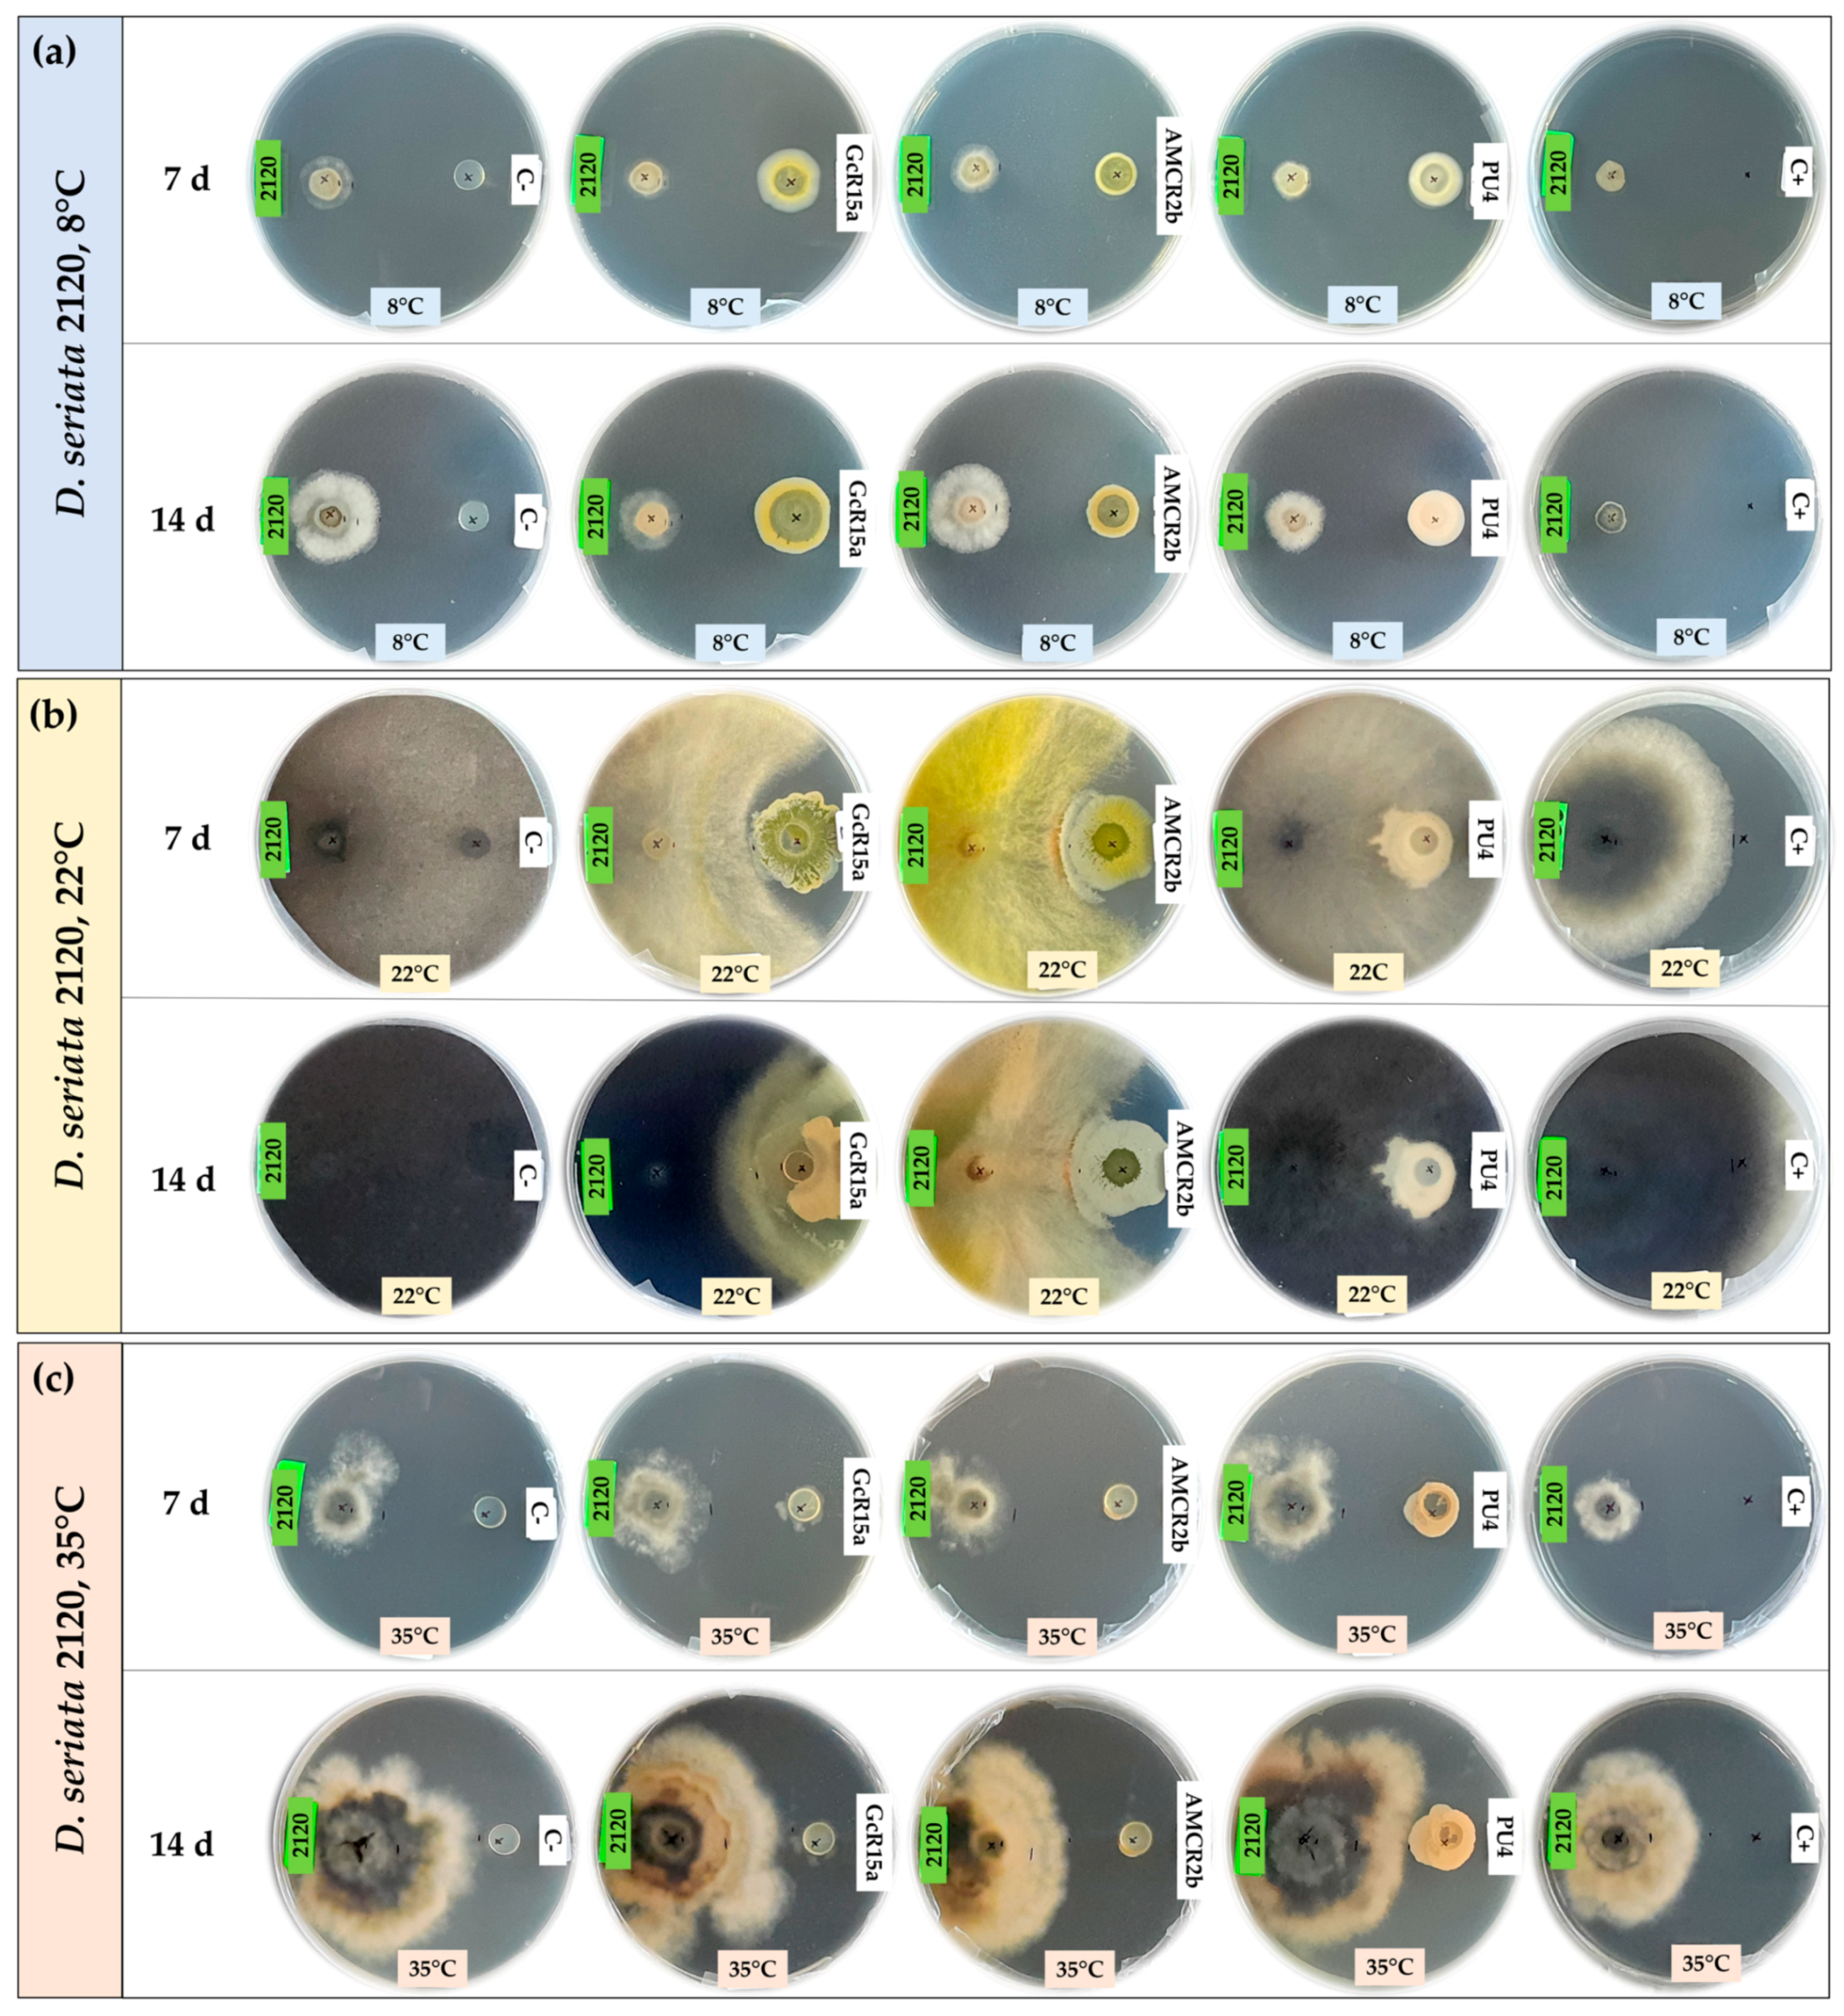
Microorganisms 12 00350 g001
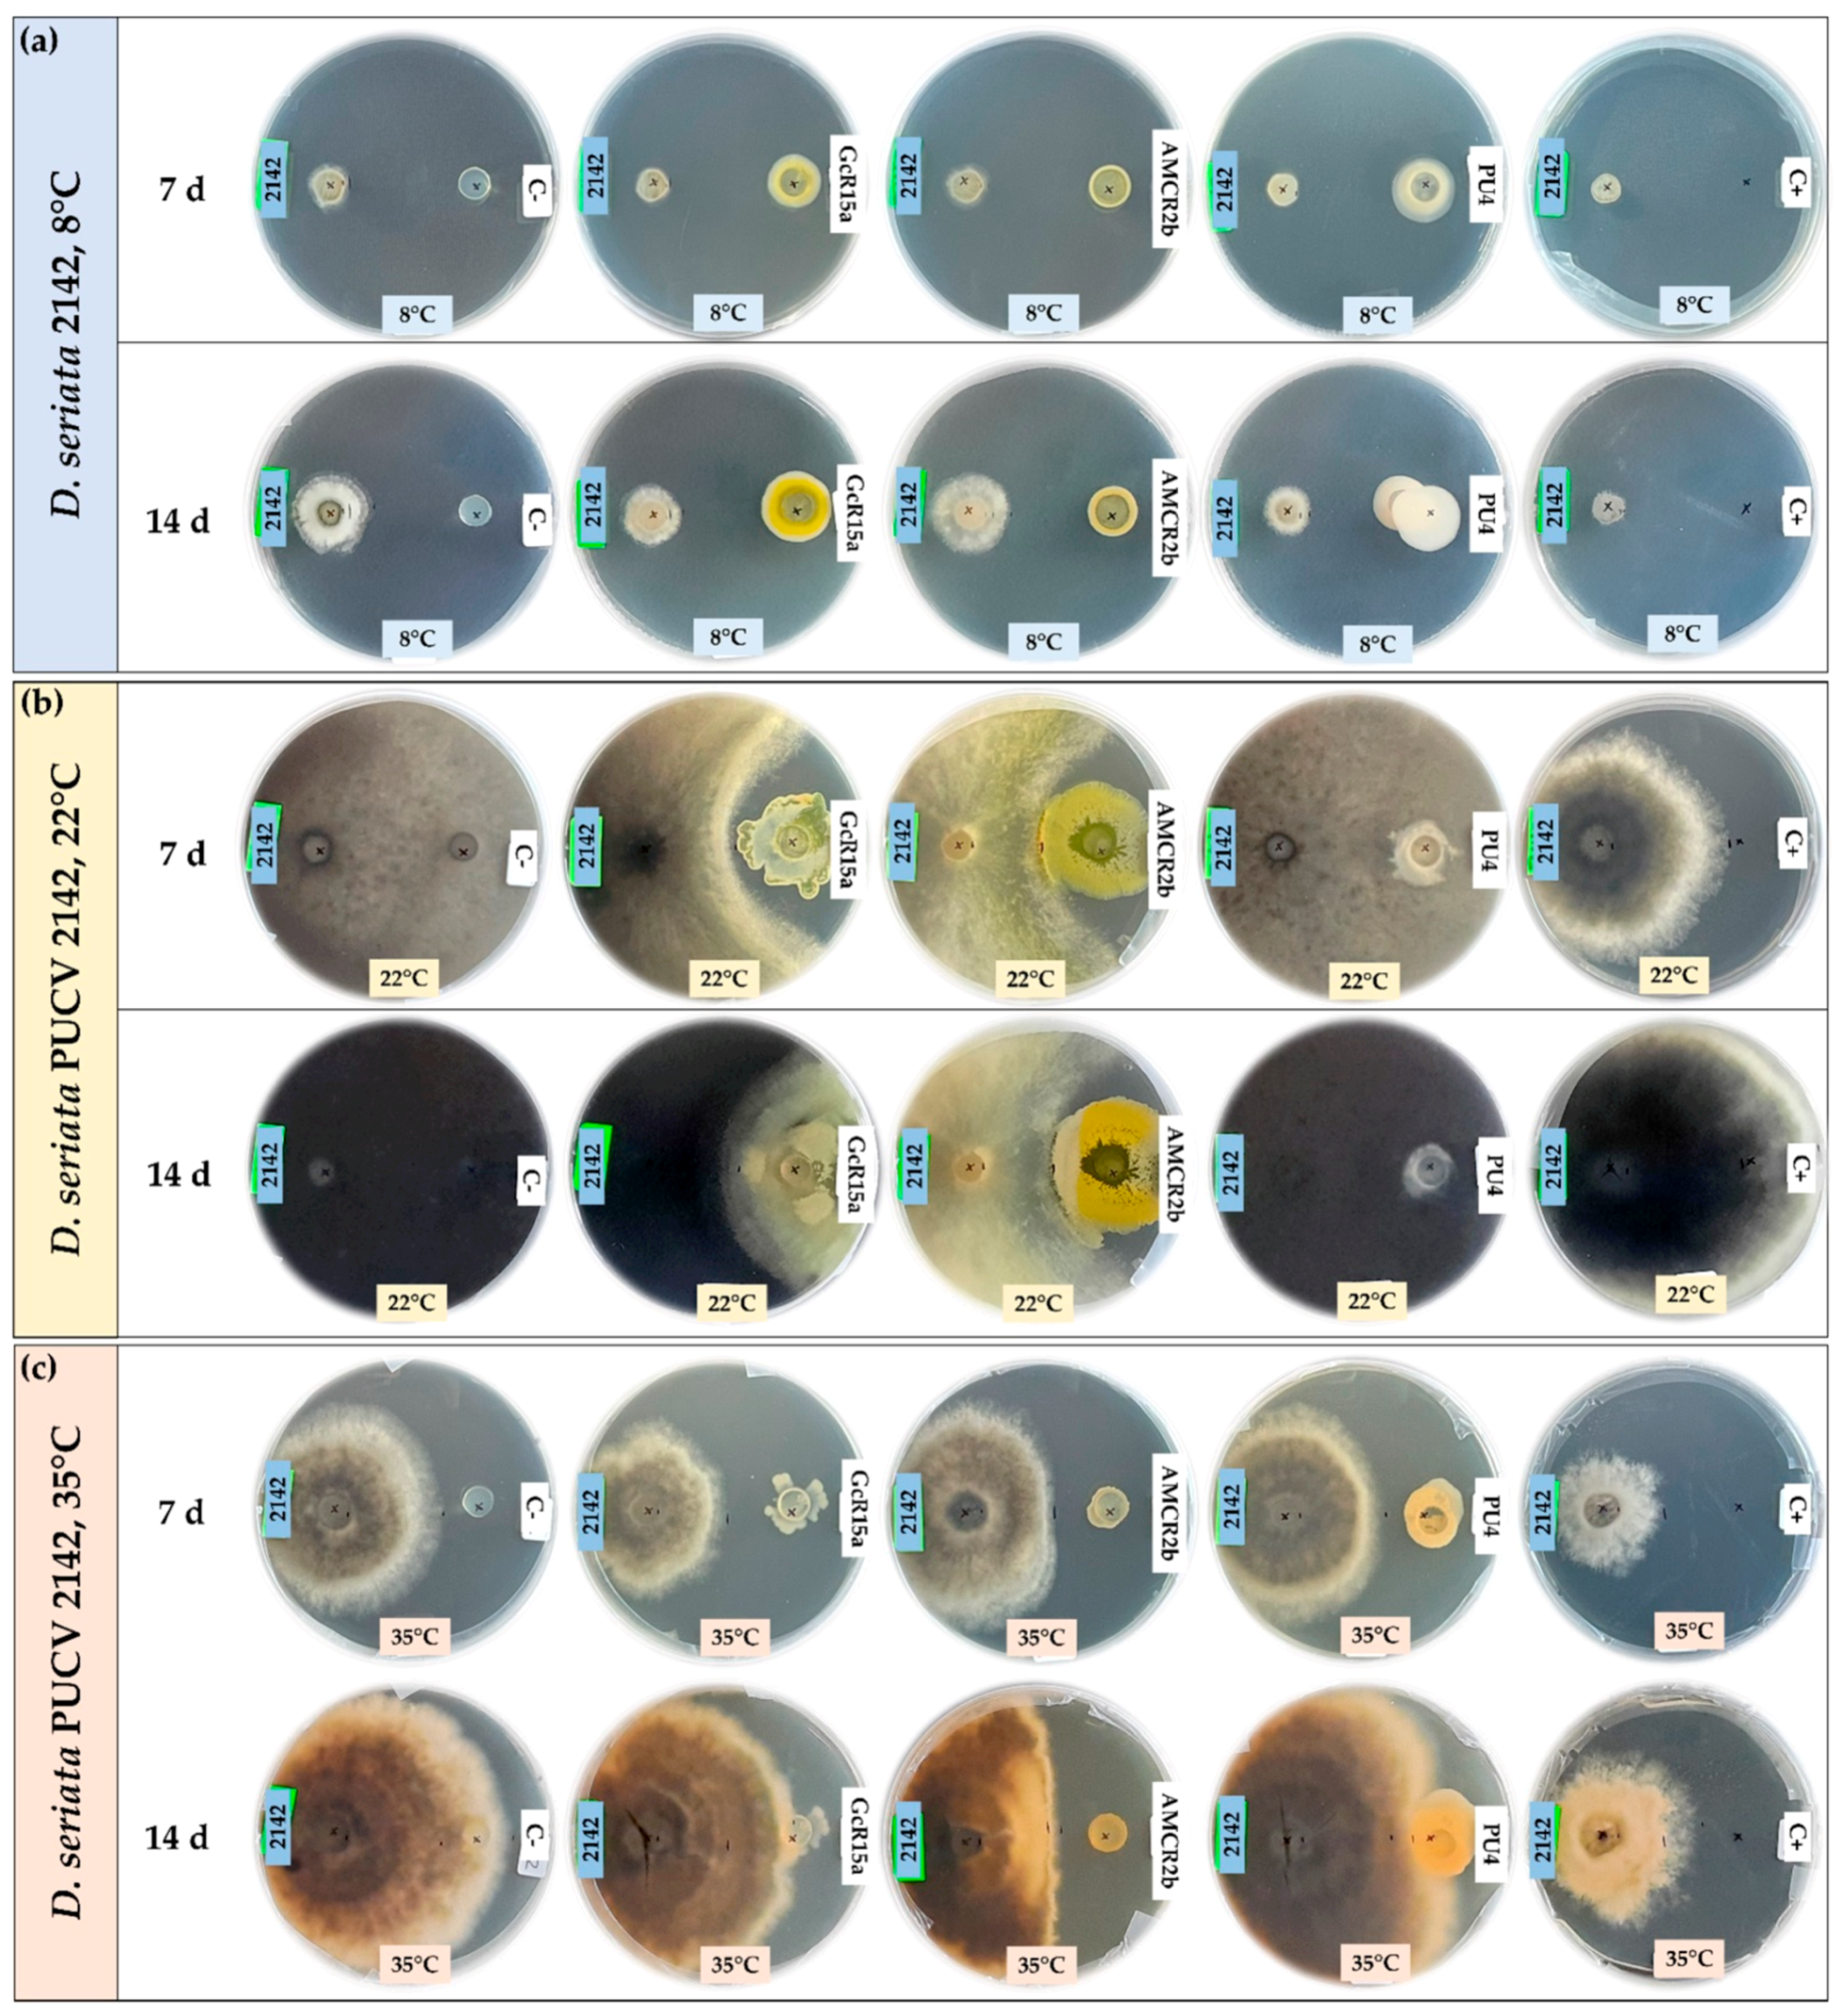
Microorganisms 12 00350 g002
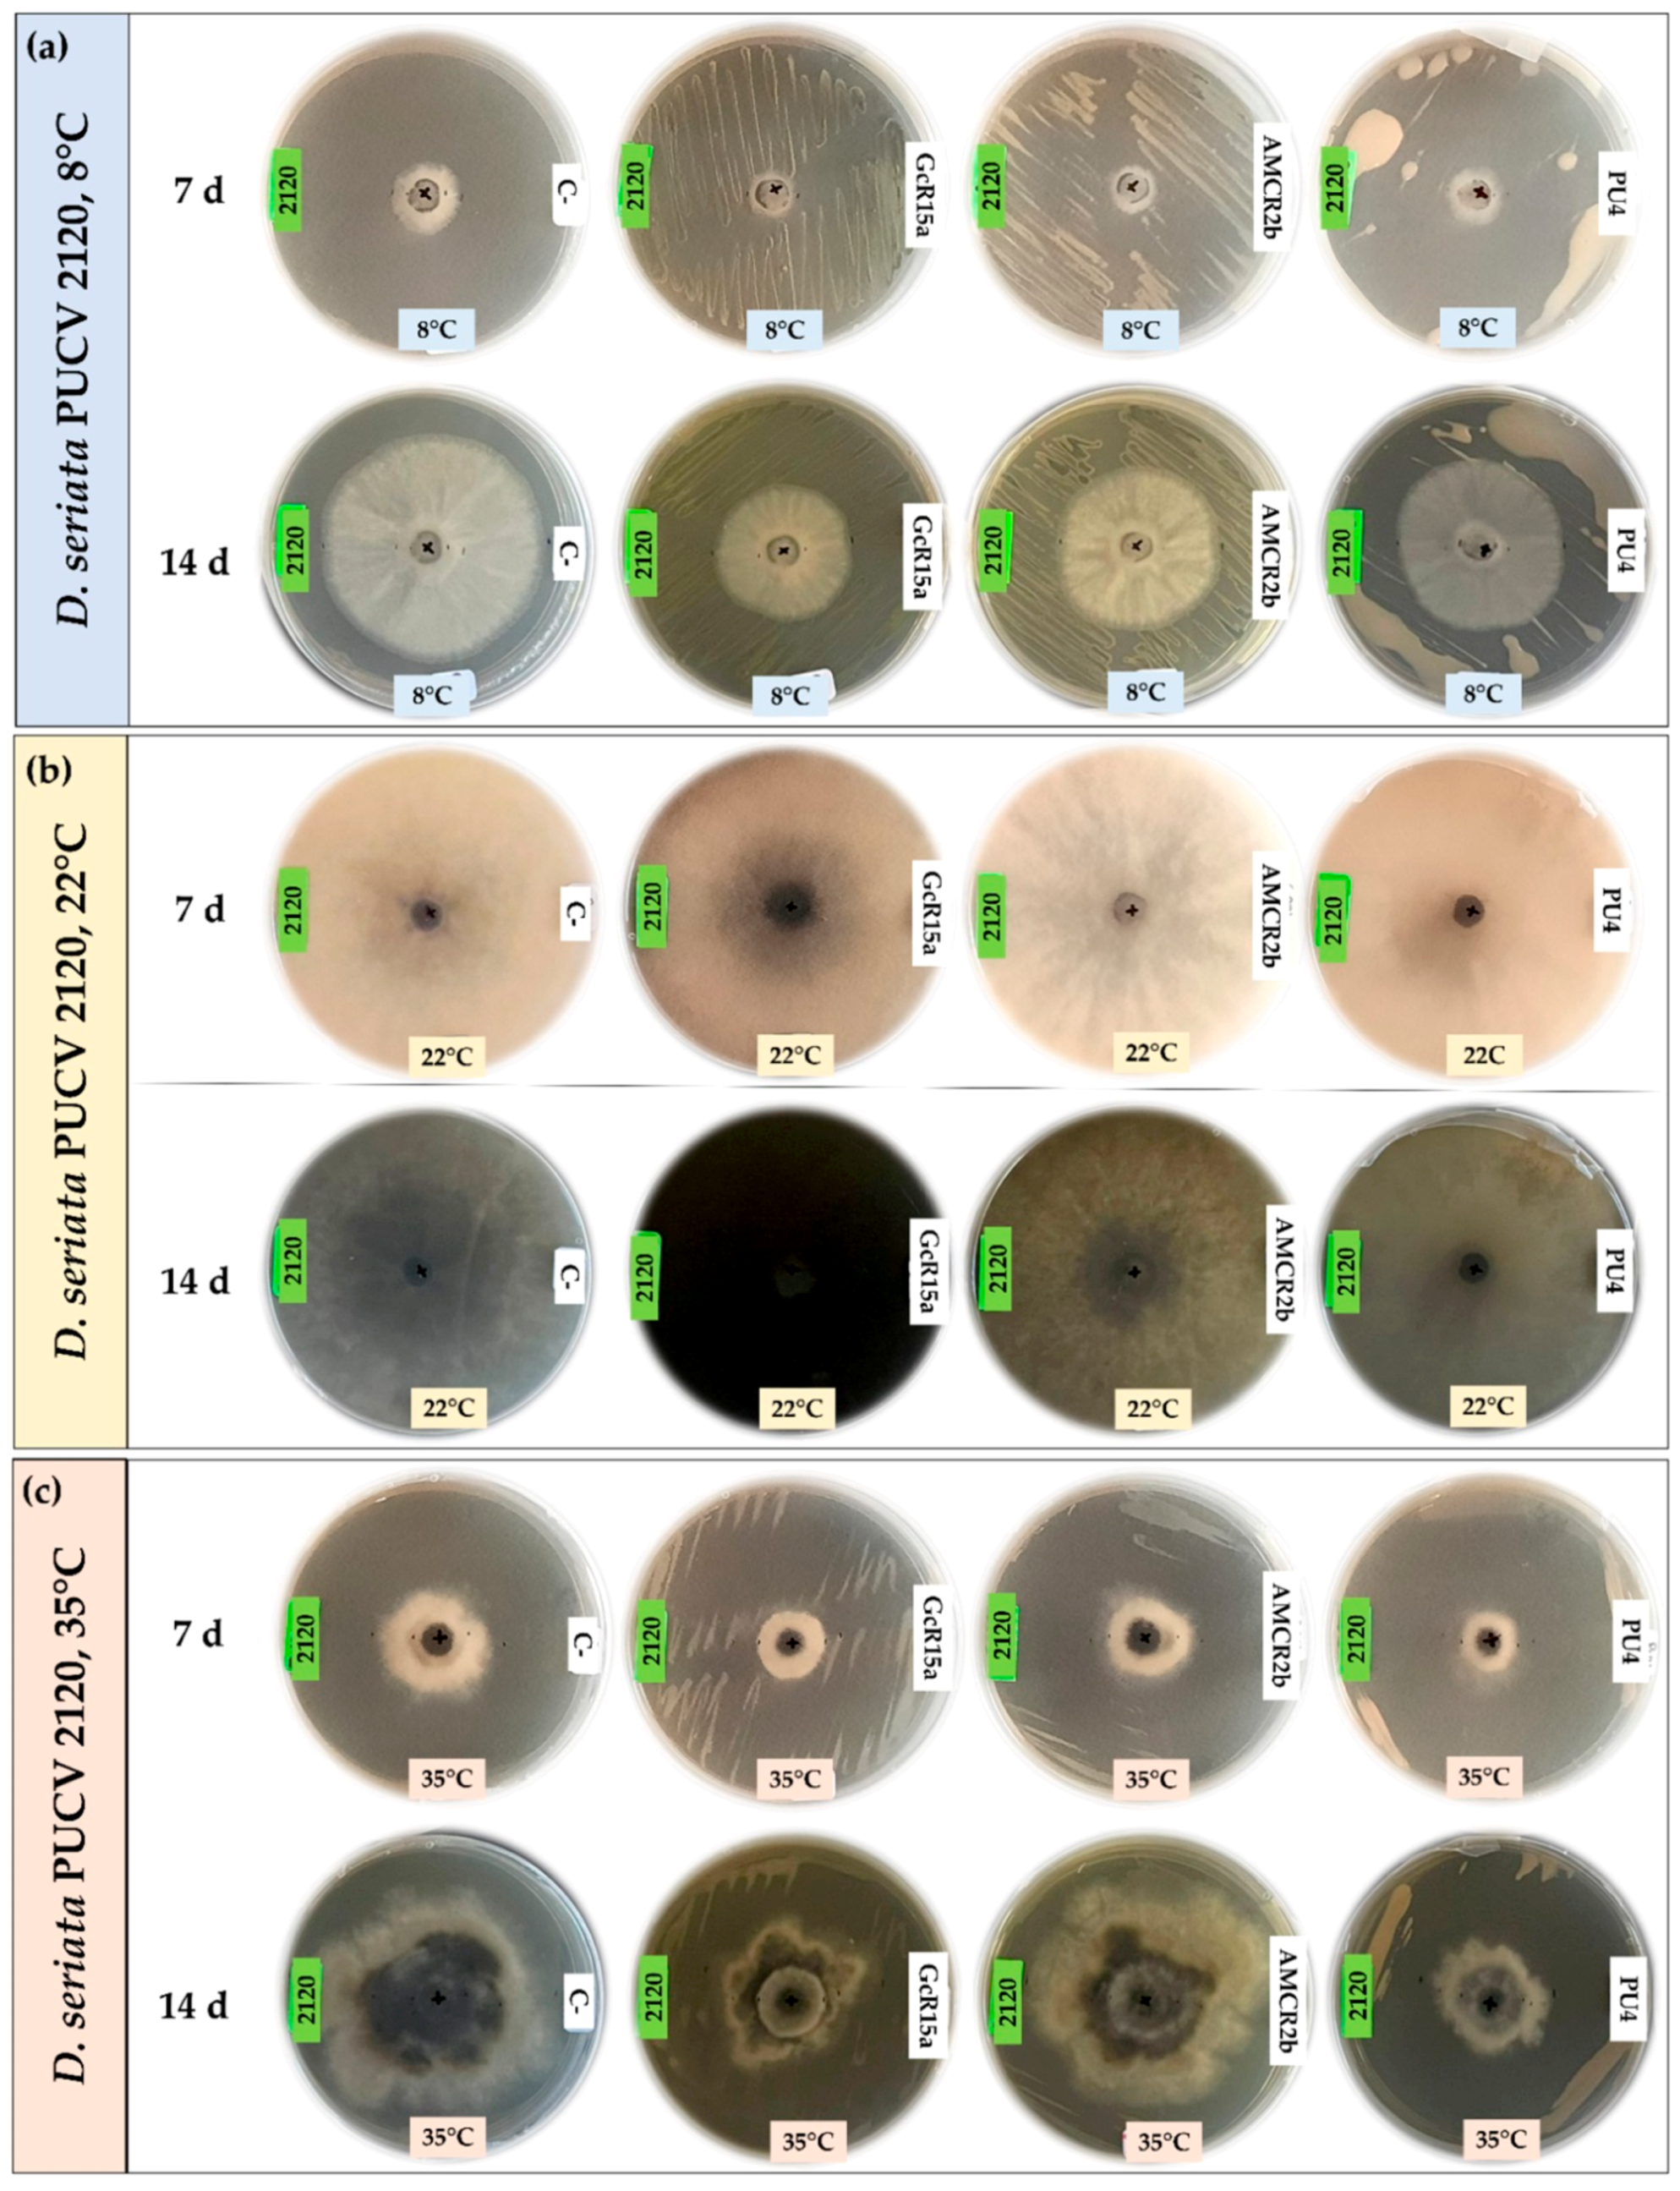
Microorganisms 12 00350 g005
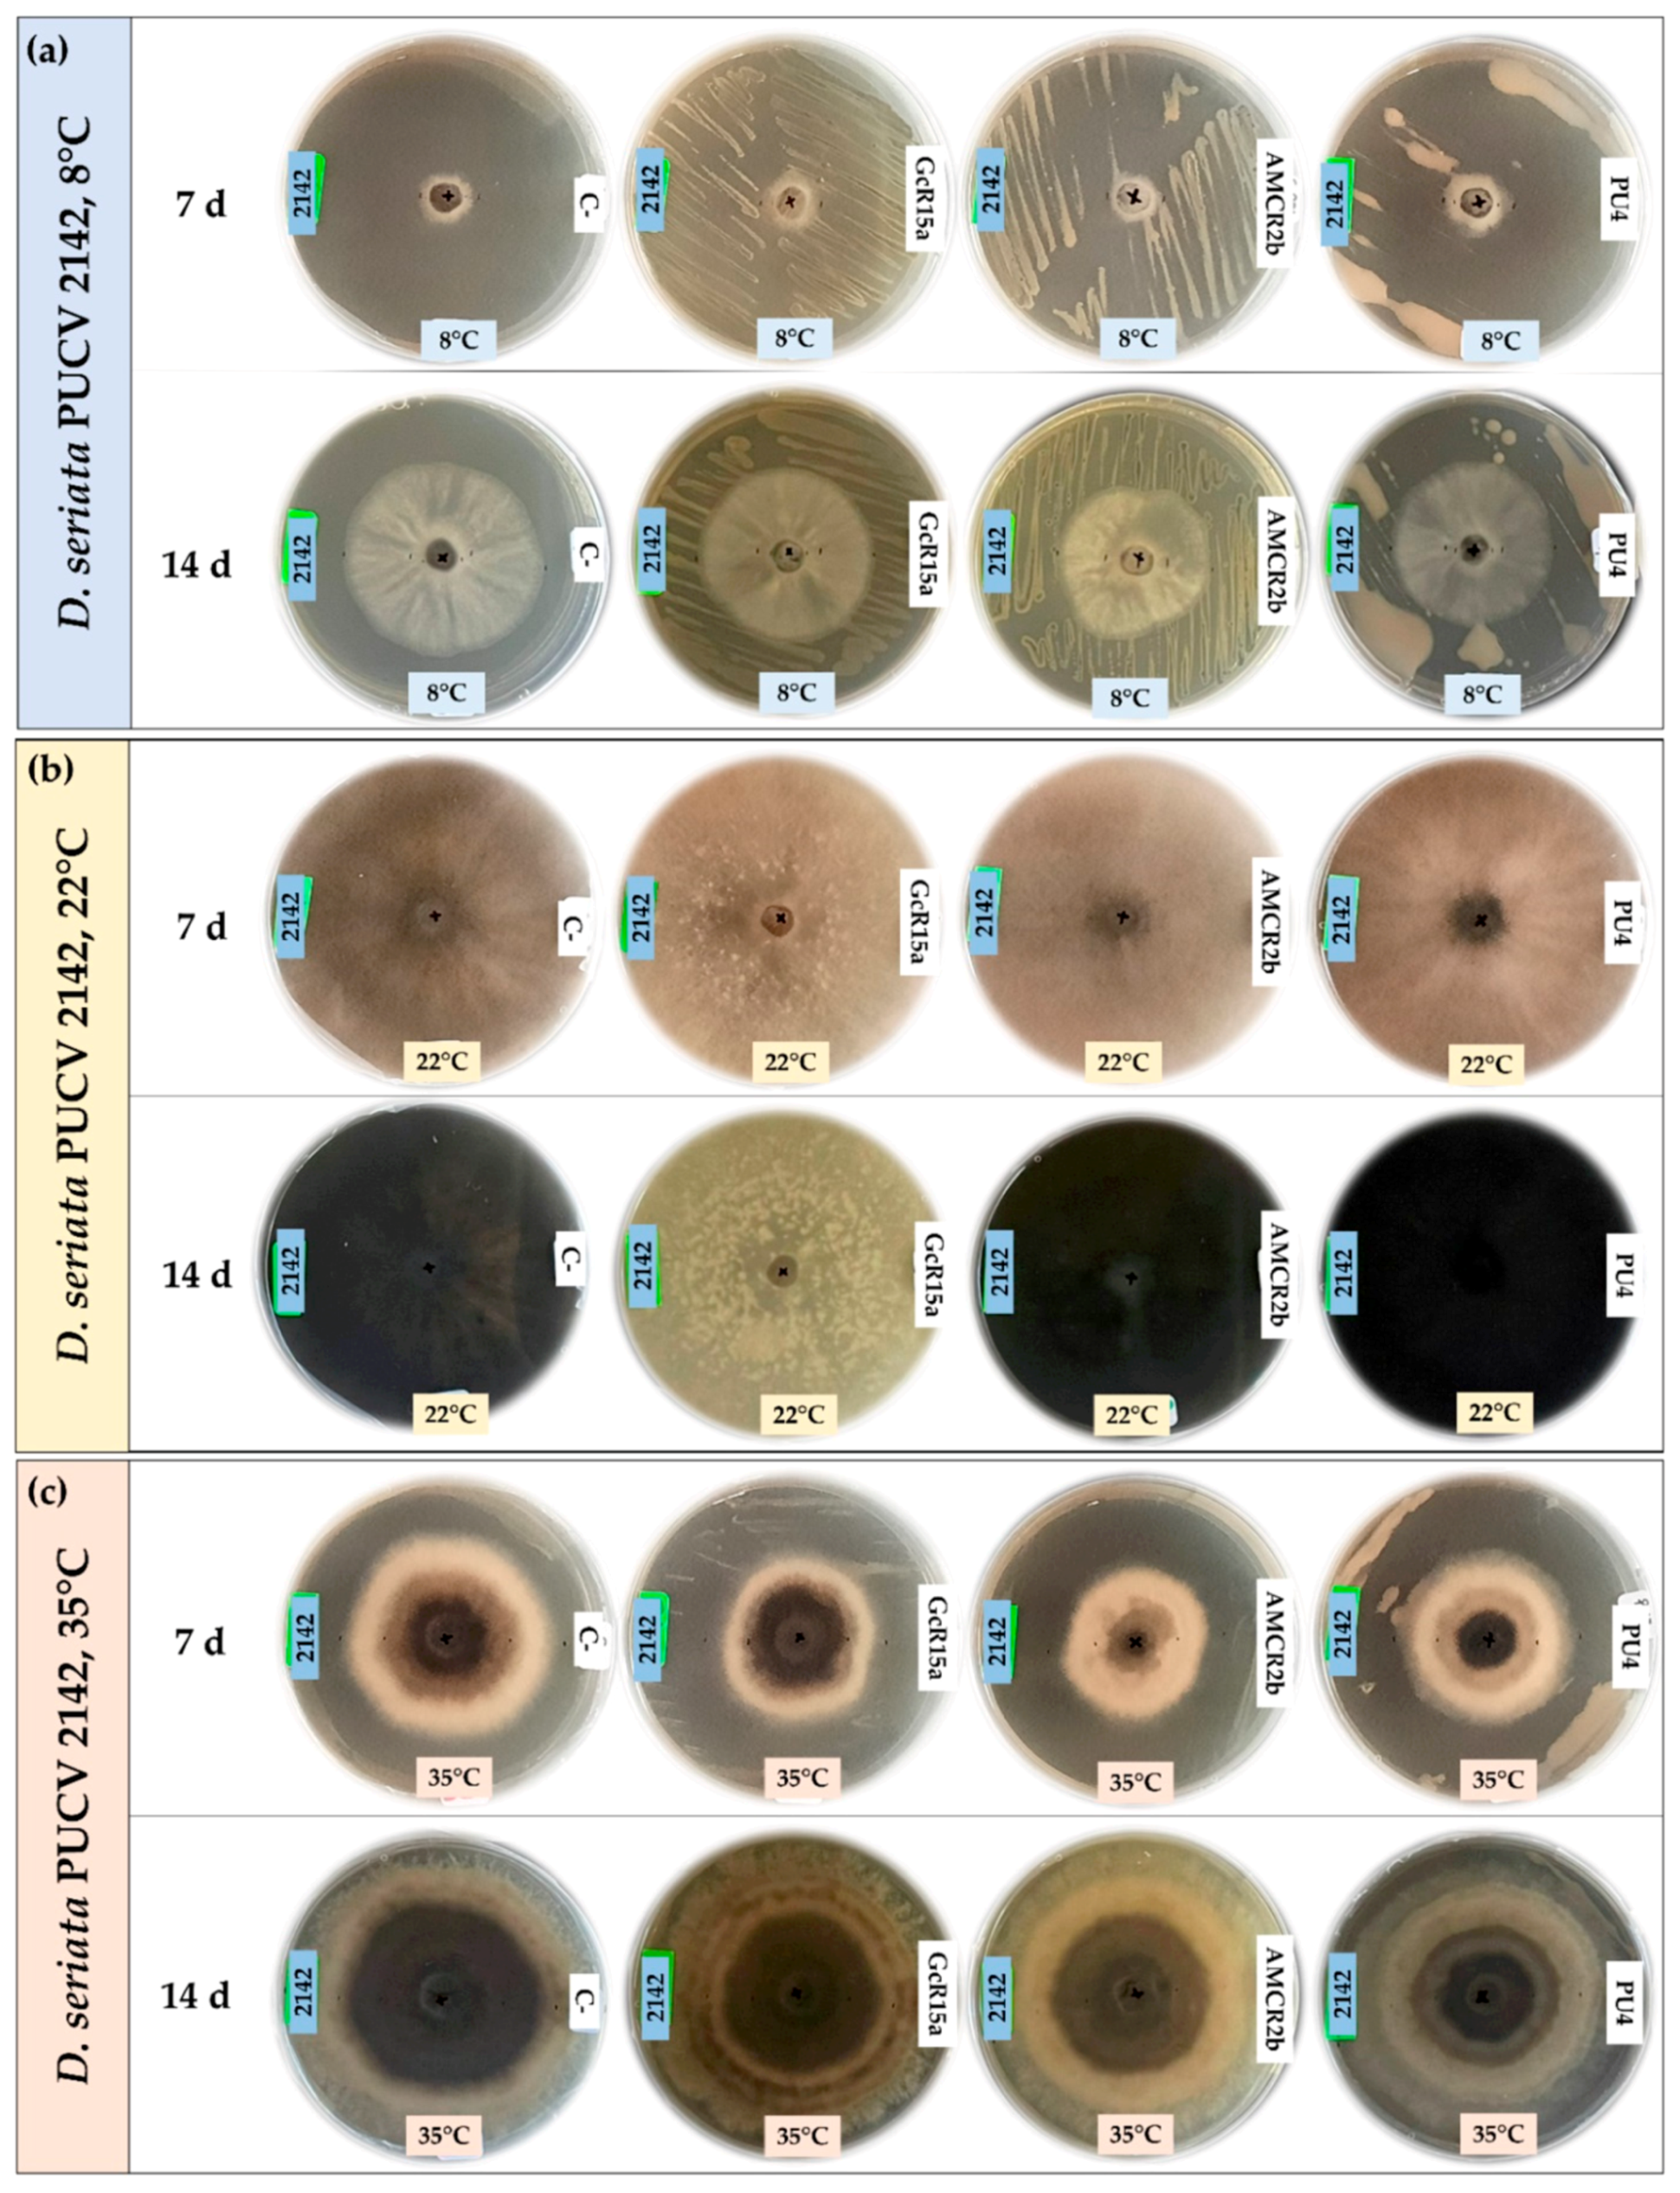
Microorganisms 12 00350 g006
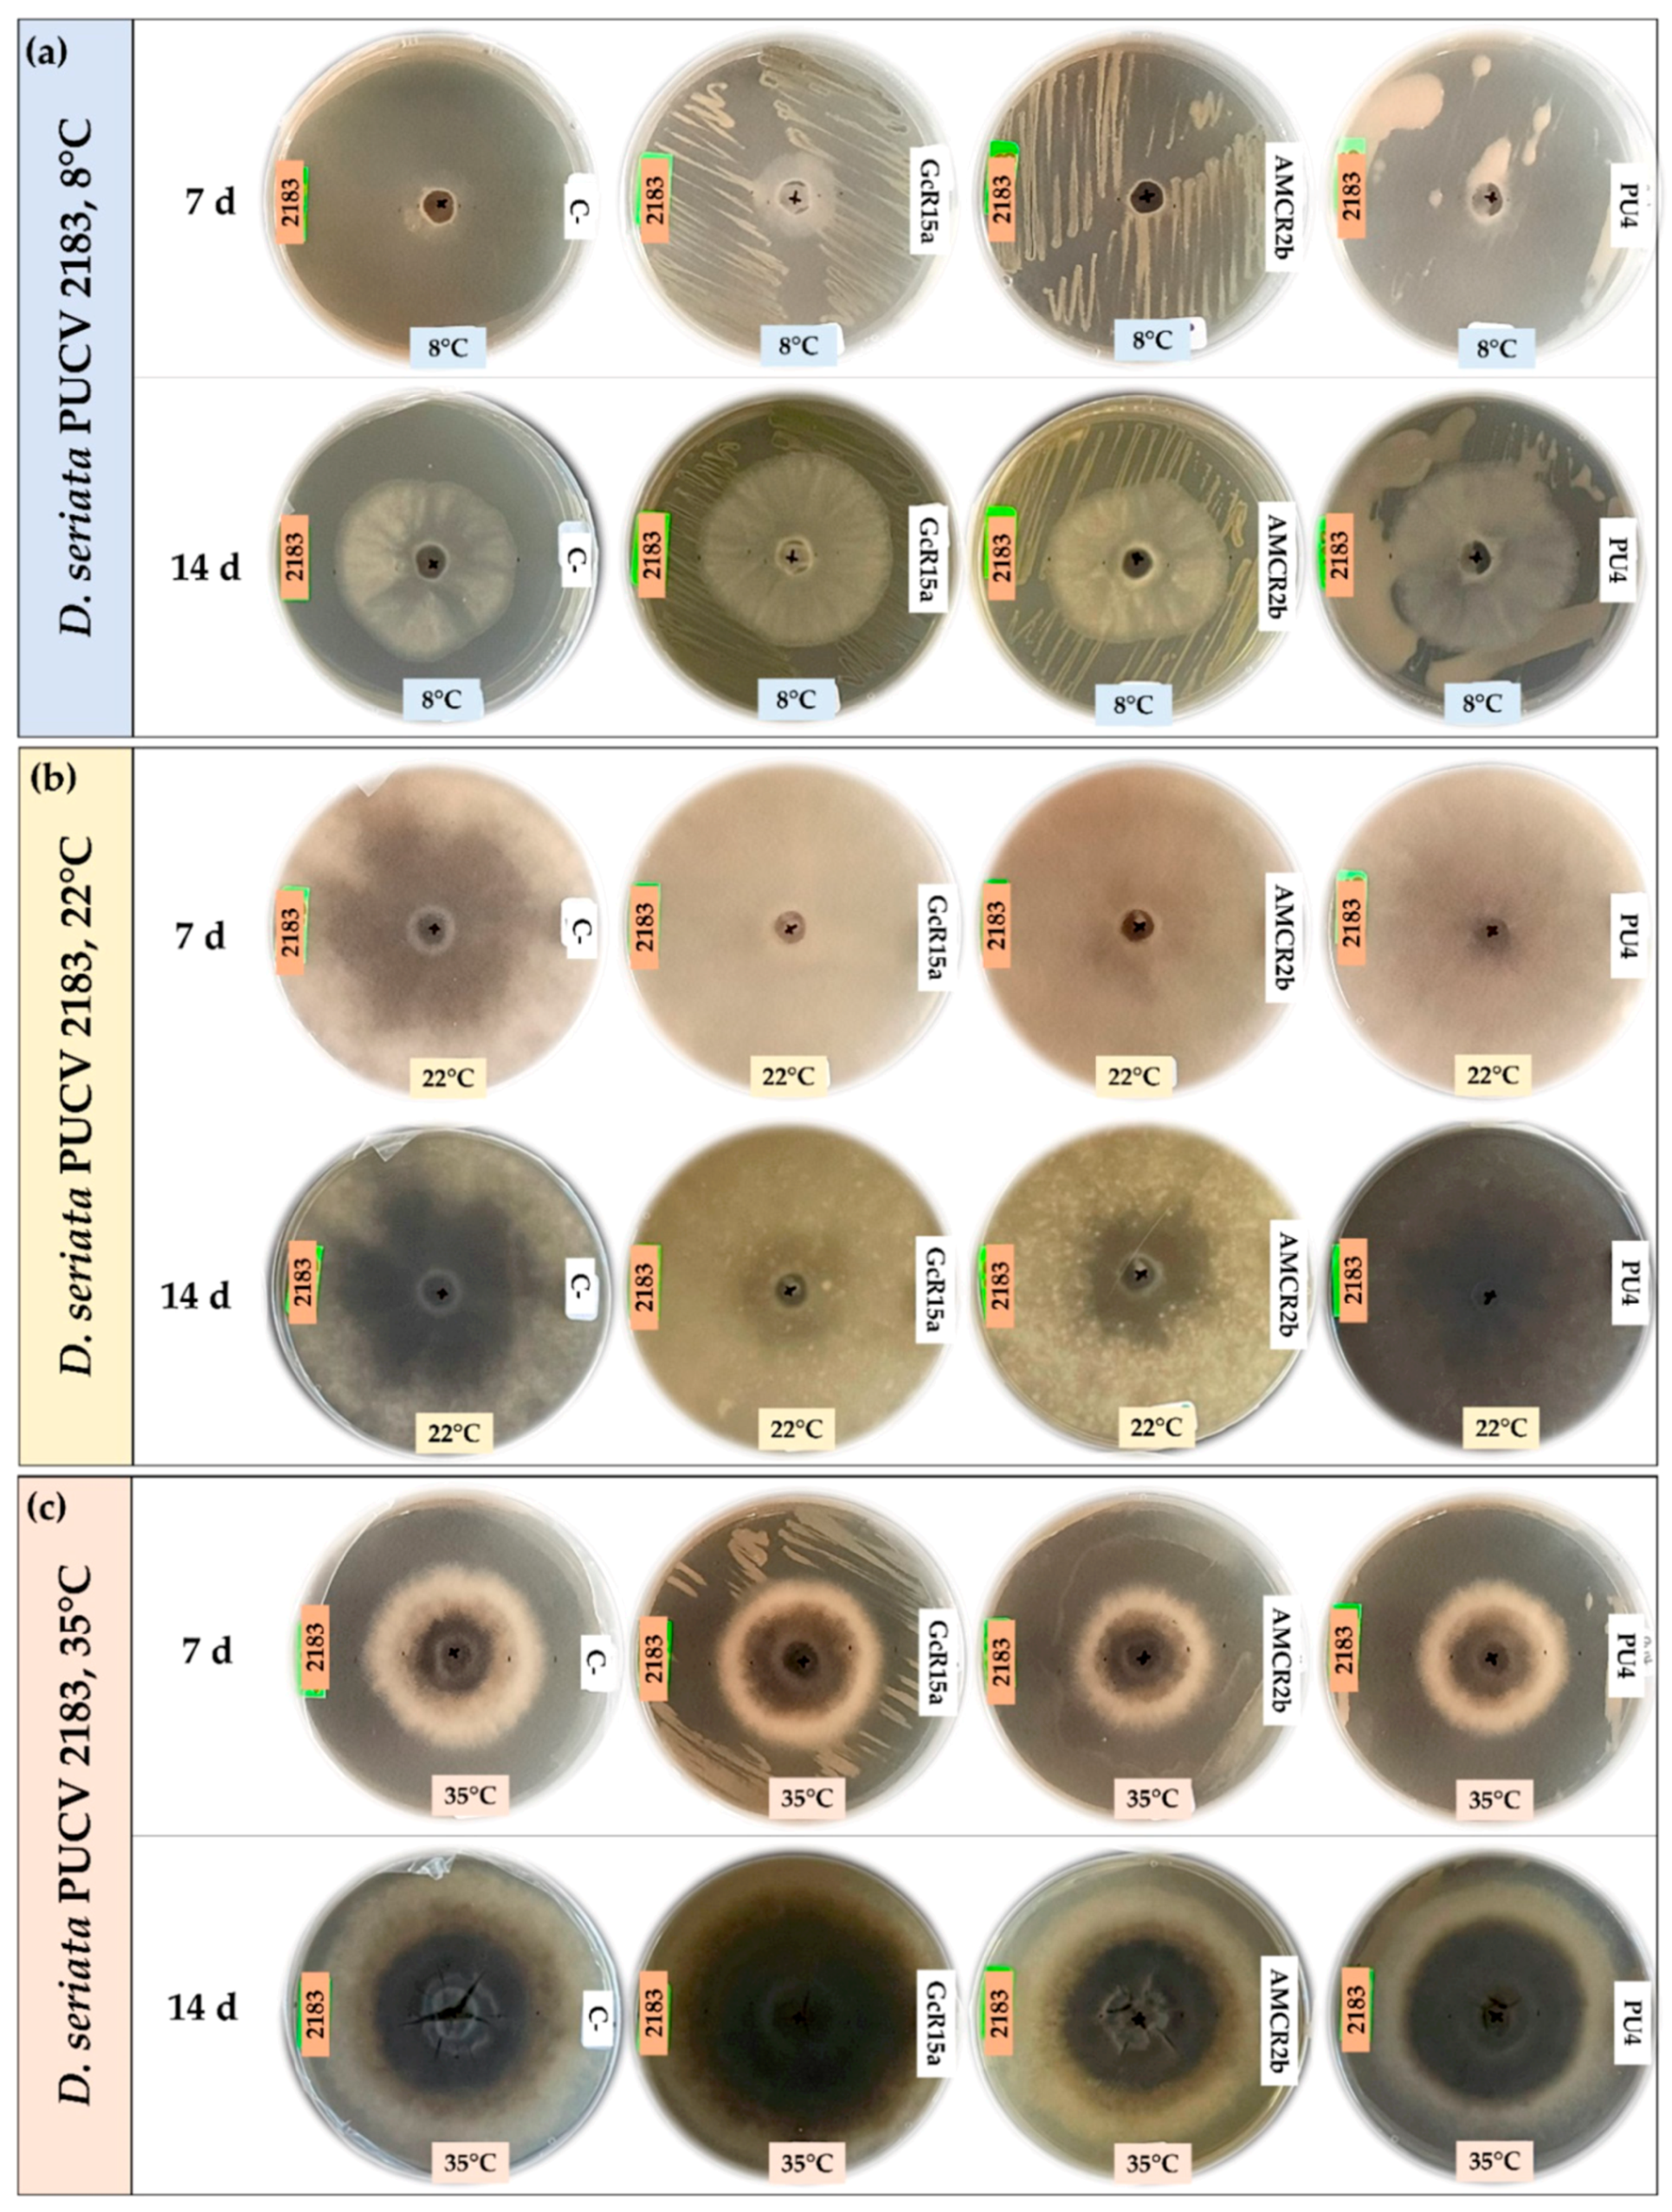
Microorganisms 12 00350 g007

Diplodia seriata Biocontrol Is Altered via Temperature and the Control of Bacteria
Abstract
1. Introduction
2. Materials and Methods
2.1. Bacteria
2.2. In Vitro Biocontrol Assay (Agar Plug Diffusion Method)
2.3. In Vitro Biocontrol Assay (Double Plate Method)
2.4. In Vivo Biocontrol Assay
2.5. Statistical Analysis
3. Results
3.1. In Vitro Biocontrol Assay (Agar Plug Diffusion Method)
3.2. In Vitro Biocontrol Assay (Double Plate Method)
3.3. Biocontrol on Grapevine Cuttings
4. Discussion
5. Conclusions
Supplementary Materials
Author Contributions
Funding
Data Availability Statement
Acknowledgments
Conflicts of Interest
References
- Sargolzaei, M.; Rustioni, L.; Cola, G.; Ricciardi, V.; Bianco, P.A.; Maghradze, D.; Failla, O.; Quaglino, F.; Toffolatti, S.L.; de Lorenzis, G. Georgian grapevine cultivars: Ancient biodiversity for future viticulture. Front. Plant Sci. 2021, 12, 630122. [Google Scholar] [CrossRef] [PubMed]
- Kenfaoui, J.; Radouane, N.; Mennani, M.; Tahiri, A.; El Ghadraoui, L.; Belabess, Z.; Fontaine, F.; El Hamss, H.; Amiri, S.; Lahlali, R.; et al. A panoramic view on Grapevine Trunk Diseases threats: Case of Eutypa Dieback, Botryosphaeria Dieback and Esca Disease. J. Fungi 2022, 8, 595. [Google Scholar] [CrossRef] [PubMed]
- Kovács, C.; Sándor, E. The increasing importance of grapevine trunk diseases. Int. J. Hortic. Sci. 2016, 22, 21–30. [Google Scholar] [CrossRef]
- Larach, A.; Torres, C.; Riquelme, N.; Valenzuela, M.; Salgado, E.; Seeger, M.; Besoain, X. Yield loss estimation and pathogen identification from Botryosphaeria dieback in vineyards of Central Chile over two growing seasons. Phytopathol. Mediterr. 2020, 59, 537–548. [Google Scholar]
- Lade, S.B.; Štraus, D.; Oliva, J. Variation in fungal community in grapevine (Vitis vinifera) nursery stock depends on nursery, variety and rootstock. J. Fungi 2022, 8, 47. [Google Scholar] [CrossRef]
- Larach, A.; Vega-Celedón, P.; Salgado, E.; Salinas, A.; Riquelme, N.; Castillo-Novales, D.; Sanhueza, P.; Seeger, M.; Besoain, X. Higher virulence of Diplodia seriata isolates on vines of cv. Cabernet Sauvignon associated with 10-Year-old wood compared to young tissue. Plants 2023, 12, 2984. [Google Scholar] [CrossRef]
- Kaplan, J.; Travadon, R.; Cooper, M.; Hillis, V.; Lubell, M.; Baumgartner, K. Identifying economic hurdles to early adoption of preventative practices: The case of trunk diseases in California winegrape vineyards. Wine Econ. Policy 2016, 5, 127–141. [Google Scholar] [CrossRef]
- Besoain, X. Grapevine Trunk Diseases (GTDs): Impact in table grapes and wine vineyards in Chile. In Grapes and Wines—Advances in Production, Processing, Analysis and Valorization; Jordao, A.M., Cosme, F., Eds.; Intechopen: London, UK, 2018; pp. 43–58. [Google Scholar]
- Gramaje, D.; Urbez-Torres, J.R.; Sosnowski, M.R. Managing grapevine trunk diseases with respect to etiology and epidemiology: Current strategies and future prospects. Plant Dis. 2018, 102, 12–39. [Google Scholar] [CrossRef]
- Úrbez-Torres, J.R. The status of Botryosphariaceae species infecting grapevines. Phytopathol. Mediterr. 2011, 50, 5–45. [Google Scholar]
- ODEPA. Oficina de Estudios y Políticas Agrarias. Rubros. Vinos. 2022. Available online: https://www.odepa.gob.cl/rubros/vinos-y-alcoholes (accessed on 6 September 2023).
- SAG. Catastro Vitícola Nacional. 2020. Available online: https://www.sag.gob.cl/noticias/sag-presenta-catastro-viticola-nacional-2020 (accessed on 6 September 2023).
- Morales, A.; Latorre, B.A.; Piontelli, E.; Besoain, X. Botryosphariaceae species affecting table grape vineyards in Chile and cultivar susceptibility. Cienc. Investig. Agrar. 2012, 39, 445–458. [Google Scholar] [CrossRef]
- Díaz, G.A.; Auger, J.; Besoain, X.; Bordeu, E.; Latorre, B.A. Prevalence and pathogenicity of fungi associated with grapevine trunk diseases in Chilean vineyards. Cienc. Investig. Agrar. 2013, 40, 327–339. [Google Scholar] [CrossRef]
- Valencia, D.; Torres, C.; Camps, R.; López, E.; Celis-Diez, J.L.; Besoain, X. Dissemination of Botryosphariaceae conidia in vineyards in the semiarid Mediterranean climate of the Valparaíso Region of Chile. Phytopathol. Mediterr. 2015, 54, 394–402. [Google Scholar]
- Úrbez-Torres, J.R.; Battany, M.; Bettiga, L.J.; Gispert, C.; McGourty, G.; Roncoroni, J.; Smith, R.J.; Verdegaal, P.; Gubler, W.D. Botryosphariaceae species spore-trapping studies in California vineyards. Plant Dis. 2010, 94, 717–724. [Google Scholar] [CrossRef] [PubMed]
- Úrbez-Torres, J.R.; Leavitt, G.M.; Guerrero, J.C.; Guevara, J.; Gubler, W.D. Identification and pathogenicity of Lasiodiplodia theobromae and Diplodia seriata, the causal agents of bot canker disease of grapevines in Mexico. Plant Dis. 2008, 92, 519–529. [Google Scholar] [CrossRef] [PubMed]
- Martín, M.T.; Cobos, R. Identification of fungi associated with grapevine decline in Castilla y León (Spain). Phytopathol. Mediterr. 2007, 46, 18–25. [Google Scholar]
- Luque, J.; Elena, G.; Garcia-Figueres, F.; Reyes, J.; Barrios, G.; Legorburu, F.J. Natural infections of pruning wounds by fungal trunk pathogens in mature grapevines in Catalonia (Northeast Spain). Aust. J. Grape Wine Res. 2014, 20, 134–143. [Google Scholar] [CrossRef]
- Reis, P.; Gaspar, A.; Alves, A.; Fontaine, F.; Lourenço, I.; Saramago, J.; Mota, M.; Rego, C. Early season symptoms on stem, inflorescences and flowers of grapevine associated with Botryosphariaceae species. Plants 2020, 9, 1427. [Google Scholar] [CrossRef]
- Kuntzmann, P.; Villaume, S.; Larignon, P.; Bertsch, C. Esca, BDA and Eutypiosis: Foliar symptoms, trunk lesions and fungi observed in diseased vinestocks in two vineyards in Alsace. Vitis 2010, 49, 71–76. [Google Scholar]
- Mohammadi, H.; Gramaje, D.; Banihashemi, Z.; Armengol, J. Characterization of Diplodia seriata and Neofusicoccum parvum associated with grapevine decline in Iran. J. Agrar. Sci. Technol. 2013, 15, 603–616. [Google Scholar]
- Choueiri, E.; Jreijiri, F.; Chlela, P.; Louvet, G.; Lecomte, P. Occurrence of grapevine declines and first report of black dead arm associated with Botryosphaeria obtusa in Lebanon. Plant Dis. 2006, 90, 115. [Google Scholar] [CrossRef]
- Ammad, F.; Benchabane, M.; Toumi, M.; Belkacem, N.; Guesmi, A.; Ameur, C.; Lecomte, P.; Merah, O. Occurrence of Botryosphariaceae species associated with grapevine dieback in Algeria. Turk. J. Agric. For. 2014, 38, 865–876. [Google Scholar] [CrossRef]
- Chebil, S.; Fersi, R.; Bouzid, M.; Quaglino, F.; Chenenaoui, S.; Melki, I.; Durante, G.; Zacchi, E.; Bahri, B.A.; Bianco, P.A.; et al. Fungi from the Diaporthaceae and Botryosphariaceae families associated with grapevine decline in Tunisia. Cienc. Investig. Agrar. 2017, 44, 127–138. [Google Scholar] [CrossRef]
- Savocchia, S.; Steel, C.C.; Stodart, B.J. Pathogenicity of Botryosphaeria species isolated from declining grapevines in sub tropical regions of eastern Australia Grapevine Trunk Disease. Vitis 2007, 46, 27–32. [Google Scholar]
- Úrbez-Torres, J.R.; Bruez, E.; Hurtado, J.; Gubler, W.D. Effect of temperature on conidial germination of Botryosphariaceae species infecting grapevines. Plant Dis. 2010, 94, 1476–1484. [Google Scholar] [CrossRef]
- Slippers, B.; Wingfield, M.J. Botryosphariaceae as endophytes and latent pathogens of woody plants: Diversity, ecology and impact. Fungal Biol. Rev. 2007, 21, 90–106. [Google Scholar] [CrossRef]
- Agrometereología, Red Agrometereológica INIA. Available online: https://agrometeorologia.cl/ (accessed on 14 August 2023).
- Mondello, V.; Songy, A.; Battiston, E.; Pinto, C.; Coppin, C.; Trotel-Aziz, P.; Clément, C.; Mugnai, L.; Fontaine, F. Grapevine trunk diseases: A review of fifteen years of trials for their control with chemicals and biocontrol agents. Plant Dis. 2018, 102, 1189–1217. [Google Scholar] [CrossRef]
- Niem, J.M.; Billones-Baaijens, R.; Stodart, B.; Savocchia, S. Diversity profiling of grapevine microbial endosphere and antagonistic potential of endophytic Pseudomonas against Grapevine Trunk Diseases. Front. Microbiol. 2020, 11, 477. [Google Scholar] [CrossRef] [PubMed]
- Silva-Valderrama, I.; Toapanta, D.; Miccono, M.d.L.A.; Lolas, M.; Díaz, G.A.; Cantu, D.; Castro, A. Biocontrol potential of grapevine endophytic and rhizospheric fungi against trunk pathogens. Front. Microbiol. 2021, 11, 614620. [Google Scholar] [CrossRef] [PubMed]
- Álvarez-Pérez, J.M.; González-García, S.; Cobos, R.; Olego, M.Á.; Ibañez, A.; Díez-Galán, A.; Garzón-Jimeno, E.; Coque, J.J.R. Use of endophytic and rhizosphere actinobacteria from grapevine plants to reduce nursery fungal graft infections that lead to young grapevine decline. Appl. Environ. Microbiol. 2017, 83, e01564-17. [Google Scholar] [CrossRef]
- Laassami, A.; Yekkour, A.; Meklat, A.; Djemouai, N.; Zitouni, A.; Mokrane, S.; Lecomte, P.; Rey, P.; Berraf-Tebbal, A. Actinobacteria associated with vineyard soils of Algeria: Classification, antifungal potential against grapevine trunk pathogens and plant growth-promoting features. Curr. Microbiol. 2020, 77, 2831–2840. [Google Scholar] [CrossRef]
- Vega-Celedón, P.; Bravo, G.; Velásquez, A.; Cid, F.P.; Valenzuela, M.; Ramírez, I.; Vasconez, I.N.; Álvarez, I.; Jorquera, M.A.; Seeger, M. Microbial diversity of psychrotolerant bacteria isolated from wild flora of Andes Mountains and Patagonia of Chile towards the selection of plant growth-promoting bacterial consortia to alleviate cold stress in plants. Microorganisms 2021, 9, 538. [Google Scholar] [CrossRef]
- Balouiri, M.; Sadiki, M.; Ibnsouda, S.K. Methods for in vitro evaluating antimicrobial activity: A review. J. Pharm. Anal. 2016, 6, 71–79. [Google Scholar] [CrossRef] [PubMed]
- Torres, C.; Latorre, B.A.; Undurraga, P.; Besoain, X. Evaluation of DMI fungicides against species of Diplodia and Neofusicoccum associated with Botryosphaeria canker of grapevine. Cienc. Investig. Agrar. 2013, 40, 131–138. [Google Scholar] [CrossRef]
- Idris, H.A.; Labuschagne, N.; Korsten, L. Screening rhizobacteria for biological control of Fusarium root and crown rot of sorghum in Ethiopia. Biol. Control 2007, 40, 97–106. [Google Scholar] [CrossRef]
- Dennis, C.; Webster, J. Antagonistic properties of species-groups of Trichoderma. II Production of volatile antibiotics. Trans. Br. Mycol. Soc. 1971, 57, 41–48. [Google Scholar] [CrossRef]
- Delgado, N.; Olivera, M.; Cádiz, F.; Bravo, G.; Montenegro, I.; Madrid, A.; Fuentealba, C.; Pedreschi, R.; Salgado, E.; Besoain, X. Volatile Organic Compounds (VOCs) produced by Gluconobacter cerinus and Hanseniaspora osmophila displaying control effect against table grape-rot pathogens. Antibiotics 2021, 10, 663. [Google Scholar] [CrossRef] [PubMed]
- Gao, Z.; Zhang, B.; Liu, H.; Han, J.; Zhang, Y. Identification of endophytic Bacillus velezensis ZSY-1 strain and antifungal activity of its volatile compounds against Alternaria solani and Botrytis cinerea. Biol. Control 2017, 105, 27–39. [Google Scholar] [CrossRef]
- Haidar, R.; Deschamps, A.; Roudet, J.; Calvo-Garrido, C.; Bruez, E.; Rey, P.; Fermaud, M. Multi-organ screening of efficient bacterial control agents against two major pathogens of grapevine. Biol. Control 2016, 92, 55–65. [Google Scholar] [CrossRef]
- Kotze, C.; van Niekerk, J.; Halleen, F.; Mostert, L.; Pourie, P. Evaluation of biocontrol agents for grapevine pruning wound protection against trunk pathogen infection. Phytopathol. Mediterr. 2011, 50, 247–263. [Google Scholar]
- Larach, A.; Riquelme, N.; Salinas, A.; Rolshausen, P.E.; Seeger, M.; Besoain, X. First report of Diaporthe ambigua associated with dead arm disease on grapevine in Chile. Plant Dis. 2022. [Google Scholar] [CrossRef]
- Boiu-Sicuia, O.-A.; Toma, R.C.; Diguță, C.F.; Matei, F.; Cornea, C.P. In Vitro Evaluation of Some Endophytic Bacillus to Potentially Inhibit Grape and Grapevine Fungal Pathogens. Plants 2023, 12, 2553. [Google Scholar] [CrossRef]
- Mukherjee, P.K.; Raghu, K. Effect of temperature on antagonistic and biocontrol potential of Trichoderma sp. on Sclerotium rolfsii. Mycopathologia 1997, 139, 151–155. [Google Scholar] [CrossRef]
- Guetsky, R.; Shtienberg, D.; Elad, Y.; Dinoor, A. Combining biocontrol agents to reduce the variability of biological control. Phytopathology 2001, 91, 621–627. [Google Scholar] [CrossRef]
- Landa, B.B.; Navas-Cortés, J.A.; Jiménez-Díaz, R.M. Influence of temperature on plant-rhizobacteria interactions related to biocontrol potential for suppression of fusarium wilt of chickpea. Plant Pathol. 2004, 53, 341–352. [Google Scholar] [CrossRef]
- Mannaa, M.; Kim, K.D. Effect of temperature and relative humidity on growth of Aspergillus and Penicillium spp. and biocontrol activity of Pseudomonas protegens AS15 against aflatoxigenic Aspergillus flavus in stored rice grains. Mycobiology 2018, 46, 287–295. [Google Scholar] [CrossRef] [PubMed]
- Elena, G.; Garcia-Figueres, F.; Reigada, S.; Luque, J. Intraspecific variation in Diplodia seriata isolates occurring on grapevines in Spain. Plant Pathol. 2015, 64, 680–689. [Google Scholar] [CrossRef]
- Rolshausen, P.E.; Úrbez-Torres, J.R.; Rooney-Latham, S.; Eskalen, A.; Smith, R.J. Evaluation of pruning wound susceptibility and protection against fungi associated whith grapevine trunk diseases. Am. J. Enol. Vitic. 2009, 60, 113–119. [Google Scholar]
- Fujiyoshi, P.T.; Lawrence, D.P.; Travadon, R.; Cooper, M.; Verdegaal, P.; Schwebs, S.; Baumgartner, K. Detection of spores of causal fungi of dieback-type trunk diseases in young, asymptomatic vineyards and mature, symptomatic vineyards. Crop Prot. 2021, 150, 105798. [Google Scholar] [CrossRef]
- Naamala, J.; Smith, D.L. Relevance of plant growth promoting microorganisms and their derived compounds, in the face of climate change. Agronomy 2020, 10, 1179. [Google Scholar] [CrossRef]
- Fadiji, A.E.; Babalola, O.O.; Santoyo, G.; Perazzolli, M. The potential role of microbial biostimulants in the amelioration of climate change-associated abiotic stresses on crops. Front. Microbiol. 2022, 12, 829099. [Google Scholar] [CrossRef] [PubMed]
- Van Niekerk, J.M.; Fourie, P.H.; Halleen, F.; Crous, P. Botryosphaeria spp. as grapevine trunk disease pathogens. Phytopathol. Mediterr. 2006, 45, 43–54. [Google Scholar]
- Úrbez-Torres, J.R.; Gubler, W.B. Susceptibility of grapevine pruning wounds to infection by Lasiodiplodia theobromae and Neofusicoccum parvum. Plant Pathol. 2011, 60, 261–270. [Google Scholar] [CrossRef]
- Hernández-León, R.; Rojas-Solís, D.; Contreras-Pérez, M.; Orozco-Mosqueda, M.d.C.; Macías-Rodríguez, L.I.; Reyes-de la Cruz, H.; Valencia-Cantero, E.; Santoyo, G. Characterization of the antifungal and plant growth-promoting effects of diffusible and volatile organic compounds produced by Pseudomonas fluorescens strains. Biol. Control 2015, 81, 83–92. [Google Scholar] [CrossRef]
- Simionato, A.S.; Navarro, M.O.P.; de Jesus, M.L.A.; Barazetti, A.R.; da Silva, C.S.; Simões, G.C.; Balbi-Peña, M.I.; de Mello, J.C.P.; Panagio, L.A.; de Almeida, R.S.C.; et al. The effect of phenazine-1-carboxylic acid on mycelial growth of Botrytis cinerea produced by Pseudomonas aeruginosa LV strain. Front. Microbiol. 2017, 8, 1102. [Google Scholar] [CrossRef] [PubMed]
- Kong, W.L.; Li, P.S.; Wu, X.Q.; Wu, T.Y.; Sun, X.R. Forest tree associated bacterial diffusible and volatile organic compounds against various phytopathogenic fungi. Microorganisms 2020, 8, 590. [Google Scholar] [CrossRef]
- Bonaterra, A.; Badosa, E.; Daranas, N.; Francés, J.; Roselló, G.; Montesinos, E. Bacteria as biological control agents of plant diseases. Microorganisms 2022, 10, 1759. [Google Scholar] [CrossRef]
- Win, K.T.; Kobayashi, M.; Tanaka, F.; Takeuchi, K.; Oo, A.Z.; Jiang, C.J. Identification of Pseudomonas strains for the biological control of soybean red crown root rot. Sci. Rep. 2022, 12, 14510. [Google Scholar] [CrossRef] [PubMed]
- Chane, A.; Barbey, C.; Robert, M.; Merieau, A.; Konto-Ghiorghi, Y.; Beury-Cirou, A.; Feuilloley, M.; Pátek, M.; Gobert, V.; Latour, X. Biocontrol of soft rot: Confocal microscopy highlights virulent pectobacterial communication and its jamming by rhodococcal quorum-quenching. Mol. Plant Microbe Interact. 2019, 32, 802–812. [Google Scholar] [CrossRef]
- Zhou, Z.; Wu, X.; Li, J.; Zhang, Y.; Huang, Y.; Zhang, W.; Shi, Y.; Wang, J.; Chen, S. A novel quorum quencher, Rhodococcus pyridinivorans XN-36, is a powerful agent for the biocontrol of soft rot disease in various host plants. Biol. Control 2022, 169, 104889. [Google Scholar] [CrossRef]
- De Oliveira, F.; Germano, M.; Van Der Sand, S. Anti-phytopathogen potential of endophytic actinobacteria isolated from tomato plants (Lycopersicon esculentum) in southern Brazil and characterization of Streptomyces sp. R18, a potential biocontrol agent. Res. Microbiol. 2010, 161, 565–572. [Google Scholar] [CrossRef]
- Rangel-Montoya, E.A.; Paolinelli, M.; Rolshausen, P.; Hernandez-Martinez, R. The role of melanin in the grapevine trunk disease pathogen Lasiodiplodia gilanensis. Phytopathol. Mediterr. 2020, 59, 549–563. [Google Scholar]
- Eisenman, H.C.; Greer, E.M.; McGrail, C.W. The role of melanins in melanotic fungi for pathogenesis and environmental survival. Appl. Microbiol. Biotechnol. 2020, 104, 4247–4257. [Google Scholar] [CrossRef] [PubMed]
- Heleno, S.A.; Ferreira, I.C.F.R.; Esteves, A.P.; Ćirić, A.; Glamočlija, J.; Martins, A.; Soković, M.; Queiroz, M.J.R.P. Antimicrobial and demelanizing activity of Ganoderma lucidum extract, p-hydroxybenzoic and cinnamic acids and their synthetic acetylated glucuronide methyl esters. Food Chem. Toxicol. 2013, 58, 95–100. [Google Scholar] [CrossRef] [PubMed]

| T °C | Pathogen | Inhibition Percentage (%) | ||||
|---|---|---|---|---|---|---|
| C+ | GcR15a | AMCR2b | PU4 | |||
| Agar plug diffusion (in vitro) | 8 °C | D. seriata 2120 | 100 | 75 | 53 | 74 |
| D. seriata 2142 | 88 | 55 | 20 | 65 | ||
| D. seriata 2183 | 100 | 40 | 26 | 55 | ||
| 22 °C | D. seriata 2120 | 0 | 56 | 56 | 0 | |
| D. seriata 2142 | 12 | 45 | 64 | 0 | ||
| D. seriata 2183 | 2 | 58 | 60 | 0 | ||
| 35 °C | D. seriata 2120 | 37 | 10 | 41 | 29 | |
| D. seriata 2142 | 48 | 12 | 43 | 27 | ||
| D. seriata 2183 | 15 | 20 | 30 | 34 | ||
| Double plate (in vitro) | 8 °C | D. seriata 2120 | - | 37 | 27 | 27 |
| D. seriata 2142 | - | 17 | 21 | 10 | ||
| D. seriata 2183 | - | 0 | 5 | 0 | ||
| 22 °C | D. seriata 2120 | - | 0 | 0 | 0 | |
| D. seriata 2142 | - | 0 | 0 | 0 | ||
| D. seriata 2183 | - | 0 | 0 | 0 | ||
| 35 °C | D. seriata 2120 | - | 20 | 9 | 42 | |
| D. seriata 2142 | - | 4 | 5 | 5 | ||
| D. seriata 2183 | - | 2 | 4 | 9 | ||
| Cuttings (in vivo) | 8 °C | D. seriata 2120 | 29 | 0 | 68 | 5 |
| D. seriata 2142 | 0 | 0 | 0 | 0 | ||
| D. seriata 2183 | 0 | 10 | 0 | 0 | ||
| 22 °C | D. seriata 2120 | 31 | 17 | 42 | 0 | |
| D. seriata 2142 | 0 | 0 | 10 | 0 | ||
| D. seriata 2183 | 64 | 27 | 63 | 75 | ||
Disclaimer/Publisher’s Note: The statements, opinions and data contained in all publications are solely those of the individual author(s) and contributor(s) and not of MDPI and/or the editor(s). MDPI and/or the editor(s) disclaim responsibility for any injury to people or property resulting from any ideas, methods, instructions or products referred to in the content. |
© 2024 by the authors. Licensee MDPI, Basel, Switzerland. This article is an open access article distributed under the terms and conditions of the Creative Commons Attribution (CC BY) license (https://creativecommons.org/licenses/by/4.0/).
Share and Cite
Larach, A.; Vega-Celedón, P.; Castillo-Novales, D.; Tapia, L.; Cuneo, I.; Cádiz, F.; Seeger, M.; Besoain, X. Diplodia seriata Biocontrol Is Altered via Temperature and the Control of Bacteria. Microorganisms 2024, 12, 350. https://doi.org/10.3390/microorganisms12020350
Larach A, Vega-Celedón P, Castillo-Novales D, Tapia L, Cuneo I, Cádiz F, Seeger M, Besoain X. Diplodia seriata Biocontrol Is Altered via Temperature and the Control of Bacteria. Microorganisms. 2024; 12(2):350. https://doi.org/10.3390/microorganisms12020350
Chicago/Turabian StyleLarach, Alejandra, Paulina Vega-Celedón, Diyanira Castillo-Novales, Lorena Tapia, Italo Cuneo, Fabiola Cádiz, Michael Seeger, and Ximena Besoain. 2024. "Diplodia seriata Biocontrol Is Altered via Temperature and the Control of Bacteria" Microorganisms 12, no. 2: 350. https://doi.org/10.3390/microorganisms12020350
APA StyleLarach, A., Vega-Celedón, P., Castillo-Novales, D., Tapia, L., Cuneo, I., Cádiz, F., Seeger, M., & Besoain, X. (2024). Diplodia seriata Biocontrol Is Altered via Temperature and the Control of Bacteria. Microorganisms, 12(2), 350. https://doi.org/10.3390/microorganisms12020350

